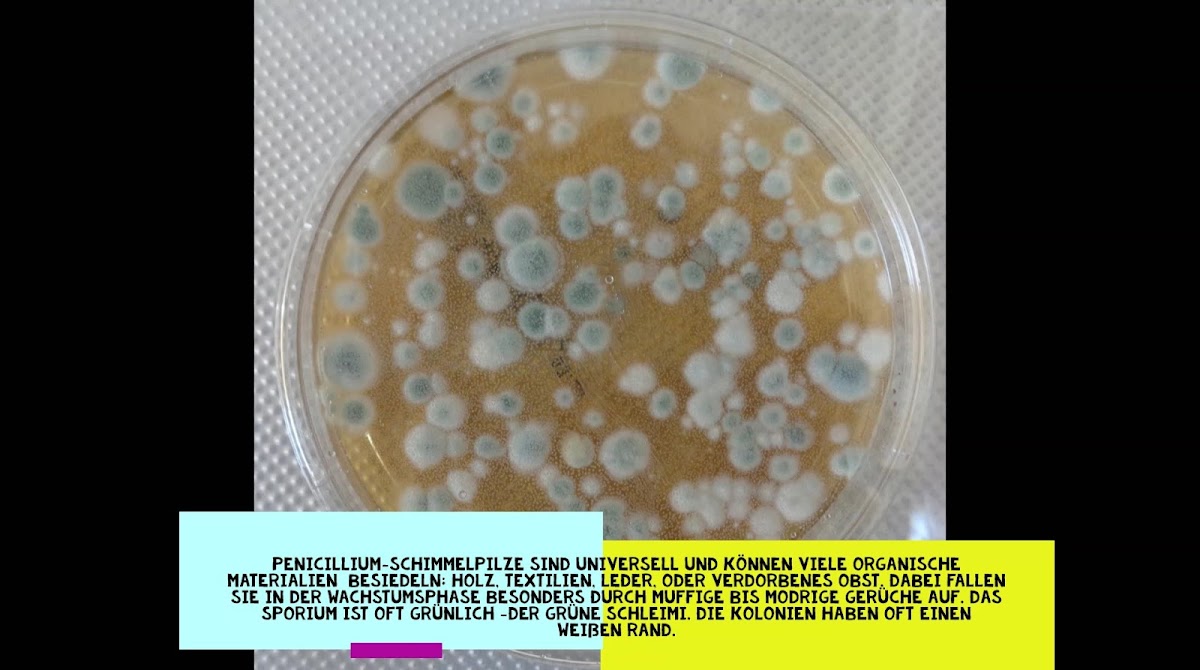
6832965e71023
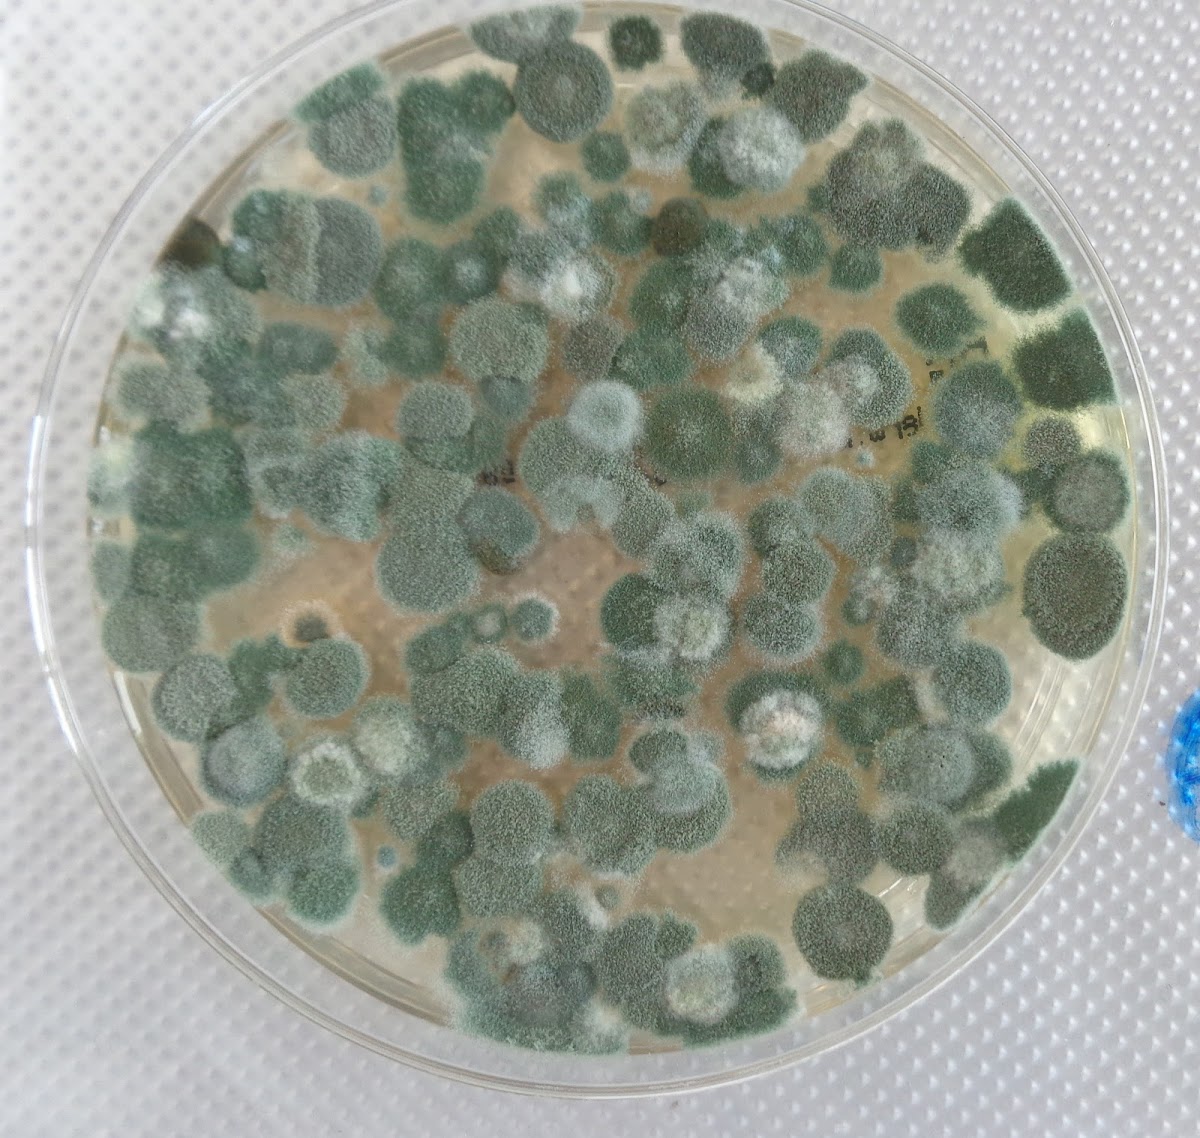
6832965f8dead

Unbekannt Unbekannt
30. March 2026
Sehr gute, professionelle Beratung. Wir können Ihn ohne Probleme weiterempfehlen.

Unbekannt Unbekannt
30. March 2026
Sehr gute, professionelle Beratung. Wir können Ihn ohne Probleme weiterempfehlen.
Andrea Eisel
30. March 2026
Herr Mehner hat uns mit seiner Expertise und Sachverstand bei der Suche nach der Ursache für feuchte Wände und Schimmel an der Außenwand kompetent und schnell weitergeholfen. Unser Hausverwalter wollte den Schimmelbefall auf falsches Nutzerverhalten schieben. Herr Mehner hat festgestellt, dass die Feuchtigkeit durch einen Baumangel entsteht und uns beraten, wie wir der Feuchtigkeit entgegenwirken können. Das hat sehr gut geklappt! Vielen Dank für die gute und fachliche Beratung! Wir können Herrn Mehner uneingeschränkt weiterempfehlen!
Dr. Wilhelm Mettner
30. March 2026
Hatte bei Mieterwechsel im Objekt Schimmelbefall an einer Wand und mehreren Fenstern. Dr. Mehner hat den Befall kurzfristig "unschädlich" gemacht, so dass der neue Mieter keine Gesundheitsschäden zu befürchten hat und eine Expertise zur Ursache geschrieben, so dass klar war, dass die Ursache falsches Nutzerverhalten der Vormieterin war und nicht Bauschäden.
Gebäudetechnik Ullrich
30. March 2026
Wir haben vor einiger Zeit mit Herrn Mehner bei einem Wasserschaden zusammenarbeiten dürfen. Dank der fachlichen Kompetenz konnte ein schwerwiegenden Schimmelbefall verhindert werden. Besten Dank für die gute Zusammenarbeit.
Joe Weiss
30. March 2026
Wer Schimmel im Haus hat wird wissen wie hilflos man sich fühlt und wie alleine man plötzlich da steht. Entgegen anderer „Handwerker“ hat der Schimmeldok innerhalb kürzester Zeit geantwortet, konkrete Fragen gestellt und sofort einige Tips zum Verhalten gegeben. Alleine das hat schon viel Druck genommen und man hat von Anfang an das Gefühl, dass man in guten Händen ist. Wenn es auch nicht zum Auftrag kam, hatten wir ein gutes Gefühl